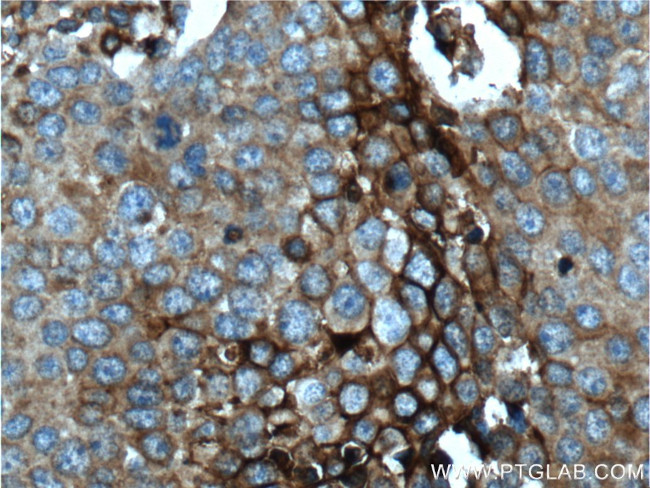
GLUT3 Antibody in Immunohistochemistry (Paraffin) (IHC (P))
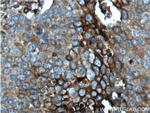
GLUT3 Antibody in Immunohistochemistry (Paraffin) (IHC (P))

Search
Proteintech
GLUT3 Polyclonal Antibody
{{$productOrderCtrl.translations['antibody.pdp.commerceCard.promotion.promotions']}}
{{$productOrderCtrl.translations['antibody.pdp.commerceCard.promotion.viewpromo']}}
{{$productOrderCtrl.translations['antibody.pdp.commerceCard.promotion.promocode']}}: {{promo.promoCode}} {{promo.promoTitle}} {{promo.promoDescription}}. {{$productOrderCtrl.translations['antibody.pdp.commerceCard.promotion.learnmore']}}
产品信息
20403-1-AP
种属反应
已发表种属
宿主/亚型
分类
类型
抗原
偶联物
形式
浓度
规格
纯化类型
保存液
内含物
保存条件
运输条件
产品详细信息
This antibody was generated against the internal region of human GLUT3 and may cross-react with GLUT14.20403-1-AP antibody detects the bands around 48-60 kDa in SDS-PAGE.
Immunogen sequence: ESPRFLLIN RKEEENAKQI LQRLWGTQDV SQDIQEMKDE SARMSQEKQV TVLELFRVSS YRQPIIISIV LQLSQQ (207-281 aa encoded by BC039196)
靶标信息
Glucose is fundamental to the metabolism of mammalian cells. Several glucose transporter protein (Glut) isoforms have been identified and shown to function in response to insulin and IGF1 induced signaling. GLUT3 is detectable in a few normal cell type spermatids in testis with active spermatogenesis, placental trophoblast membranes, and neurons in brain. GLUT3 staining is also detectable in human cancers including those of the ovary, lung, and testis.
仅用于科研。不用于诊断过程。未经明确授权不得转售。
生物信息学
蛋白别名: FLJ90380; glucose transporter 3; Glucose transporter type 3, brain; glucose transporter-like protein; GLUT-3; SLC2A3; solute carrier family 2 (facilitated glucose transporter), member 3; Solute carrier family 2 A3 (neuron glucose transporter); Solute carrier family 2, facilitated glucose transporter member 3; solute carrier family 2, member 2; solute carrier family 2, member 3; unnamed protein product
基因别名: AA408729; AL023014; AL024341; AU040424; C78366; Glut-3; GLUT3; SLC2A3
UniProt ID: (Human) P11169, (Mouse) P32037, (Rat) Q07647
Entrez Gene ID: (Human) 6515, (Mouse) 20527, (Rat) 25551